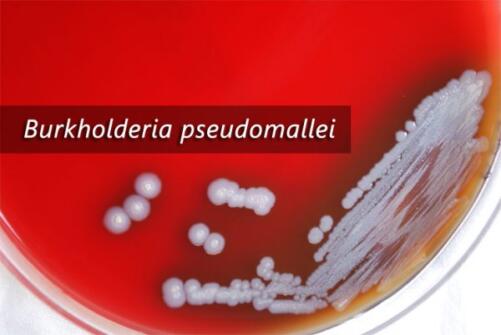

Khám phá siêu vi khuẩn “sát thủ” ở Việt Nam, có thể giết chết bạn trong vòng 2 ngày
Trong chiến tranh Việt Nam, vi khuẩn B. pseudomallei được lính Mỹ gọi với cái tên “quả bom Việt Nam nổ chậm“. Nó có thể xâm nhập não bộ và giết chết bạn chỉ trong vòng 2 ngày….

Bạn đang có một kỳ nghỉ tuyệt vời ở Việt Nam, Campuchia hay Thái Lan. Đó là một buổi sáng trong lành và bạn chỉ muốn hít một hơi thật sâu. Hãy chắc chắn bạn làm điều này ở một ban công sạch sẽ, chứ không phải trong một khu vườn ẩm thấp.
Burkholderia pseudomallei, một siêu vi khuẩn gram âm, có thể đang chờ đợi ở đâu đó, trong đất và trong nước. “Hãy tưởng tượng ai đó chỉ đang đi bộ loanh quanh và vô tình hít nó lên từ đất. Ngày hôm sau, siêu vi khuẩn này đã có mặt trong não họ và làm hư hại tủy sống”, Tiến sĩ James St John, đến từ Đại học Griffith, Australia cho biết.
Trong chiến tranh Việt Nam, B. pseudomallei được lính Mỹ gọi với cái tên “quả bom Việt Nam nổ chậm“. Nó có thể xâm nhập não bộ và giết chết bạn chỉ trong vòng 2 ngày. Nhưng làm thế nào siêu vi khuẩn này có thể thực hiện điều đó? Bí ẩn cho đến giờ mới được giải đáp bởi tiến sĩ John và các đồng nghiệp.
Nghiên cứu của ông vừa được đăng tải trên tạp chí Immunity and Infection sẽ nói cho chúng ta biết điều đó.

B. pseudomallei là loại siêu vi khuẩn gây bệnh phổ biến ở miền Bắc Australia và Đông Nam Á. Nó gây ra một căn bệnh có tên Melioidosis, đặc trưng bởi tình trạng viêm phổi, nhiễm khuẩn máu, nhiễm trùng tản mạn và khu trú như áp xe cơ, viêm hạch, viêm xương…
Người bệnh Melioidosis có tỷ lệ tử vong rất cao, do vi khuẩn B. pseudomallei kháng hầu hết các loại kháng sinh thông thường, từ penicillin, ampicillin, cephalosporin thế hệ 1 và 2 cho đến gentamicin, tobramycin, streptomycin, polymyxin. Khoảng 20-50% bệnh nhân ở Austraila sẽ tử vong, khi vi khuẩn xâm nhập não bộ.
Ở khu vực Đông Nam Á, 50% dân số được dự đoán nằm trong diện tác động của Melioidosis. Tỷ lệ tử vong ở một số nước như Campuchia có thể lên đến 50%. Khu vực nóng nhất của căn bệnh này là phía đông bắc Thái Lan, nơi cứ 100.000 dân sẽ có 50 người mắc bệnh.
Việt Nam là quốc gia nằm trong vùng dịch tễ của Melioidosis. Các trường hợp bệnh nhân đầu tiên được ghi nhận từ những năm đất nước còn là thuộc địa của Pháp. Tuy nhiên cho đến nay, báo cáo về bệnh Melioidosis còn rất hạn chế.

Thông thường, vi khuẩn B. pseudomallei được tìm thấy trong đất và nước bị ô nhiễm. “Vào mùa khô, vi khuẩn sống sống sâu bên dưới bề mặt đất. Nhưng sau một trận mưa, sẽ có nhiều hơn vi khuẩn được đưa lên bề mặt. Điều này đặt ra một nguy cơ tiếp xúc lớn với con người”, Tiến sĩ Vicki Krause, giám đốc Trung tâm kiểm soát dịch bệnh Australia cho biết.
Nghiên cứu mới của Tiến sĩ James St John đã tập trung vào tìm hiểu con đường dẫn đến cái chết khi bạn nhiễm khuẩn B. pseudomallei. Ban đầu, nó có thể xâm nhập cơ thể hiệu quả thông qua những vết thương hở tiếp xúc với đất hoặc nước ô nhiễm. Nhưng đáng lo ngại hơn, bạn cũng có thể nhiễm B. pseudomallei qua đường hô hấp.
Từ lâu, chúng ta đã biết được mối nguy hiểm này. Nhưng cách mà B. pseudomallei đi từ khoang mũi tới não vẫn là một bí ẩn. Mỗi điều chúng ta không biết về căn bệnh, khả năng điều trị nó sẽ bị giảm xuống.
Tuy nhiên, bây giờ, Tiến sĩ John và các đồng nghiệp đã có thể khám phá ra điều đó. Bằng các thí nghiệm trên chuột, ông đã có thể khám phá ra con đường mà B. pseudomallei đi từ niêm mạc mũi qua các dây thần kinh để tới thân não và sau đó vào tủy sống.
“Kết quả mới nhất của chúng tôi là lần đầu tiên con người có thể xem được quá trình vi khuẩn đi từ niêm mạch khứu giác, vào hệ thần kinh trung ương thông qua những dây thần kinh chia ba”, Giáo sư Ifor Beacham đến từ Viện Glycomics, đồng tác giả nghiên cứu cho biết.

Sau đó, điều gì sẽ xảy ra? Tiến sĩ John giải thích: “Vi khuẩn có thể ngồi yên ở đó và chờ đợi một thời điểm thích hợp để phát bệnh. Hoặc nó cũng có thể gây ra những tổn thương dần dần trong suốt cuộc đời. Bạn có thể mất chức năng não bộ từng bước một”.
Thời gian ủ bệnh ngắn nhất được ghi nhận chỉ trong 1 ngày. Trái lại, trường hợp dài nhất tới 62 năm. Nhưng thông thường, đó là khoảng từ 1-21 ngày, với con số trung bình là 9. “Vi khuẩn có thể nhiễm ở mức rất thấp. Cơ thể thậm chí không biết rằng chúng đang ở đó. Bạn có thể mang bệnh mà không hề hay biết”, Tiến sĩ John nói.

Bây giờ, với các hiểu biết mới về cách siêu vi khuẩn B. pseudomallei gây hại cho cơ thể, các nhà khoa học tin rằng một loại vắc-xin hứa hẹn trong tương lai có thể được điều chế để chống lại cơ chế gây bệnh của nó.
Trong bối cảnh các loại kháng sinh mất tác dụng với siêu vi khuẩn gram âm này, một phương pháp điều trị mới có thể ra đời. Các nhà khoa học nói họ đang tìm cách để kích thích các tế bào hỗ trợ có thể loại bỏ được vi khuẩn.
Cho tới nay, B. pseudomallei đang giết chết gần 90.000 người mỗi năm trên toàn thế giới. Trong năm 2016, khu vực Đông Nam Á và Thái Bình Dương được dự đoán sẽ có 138.000 ca mắc Melioidosis. Một nửa trong số bệnh nhân sẽ tử vong.
Theo genk
Điều Cần Biết bank Squaland
Mua Bán Squaland
Nhà Tốt Squaland
News Squaland